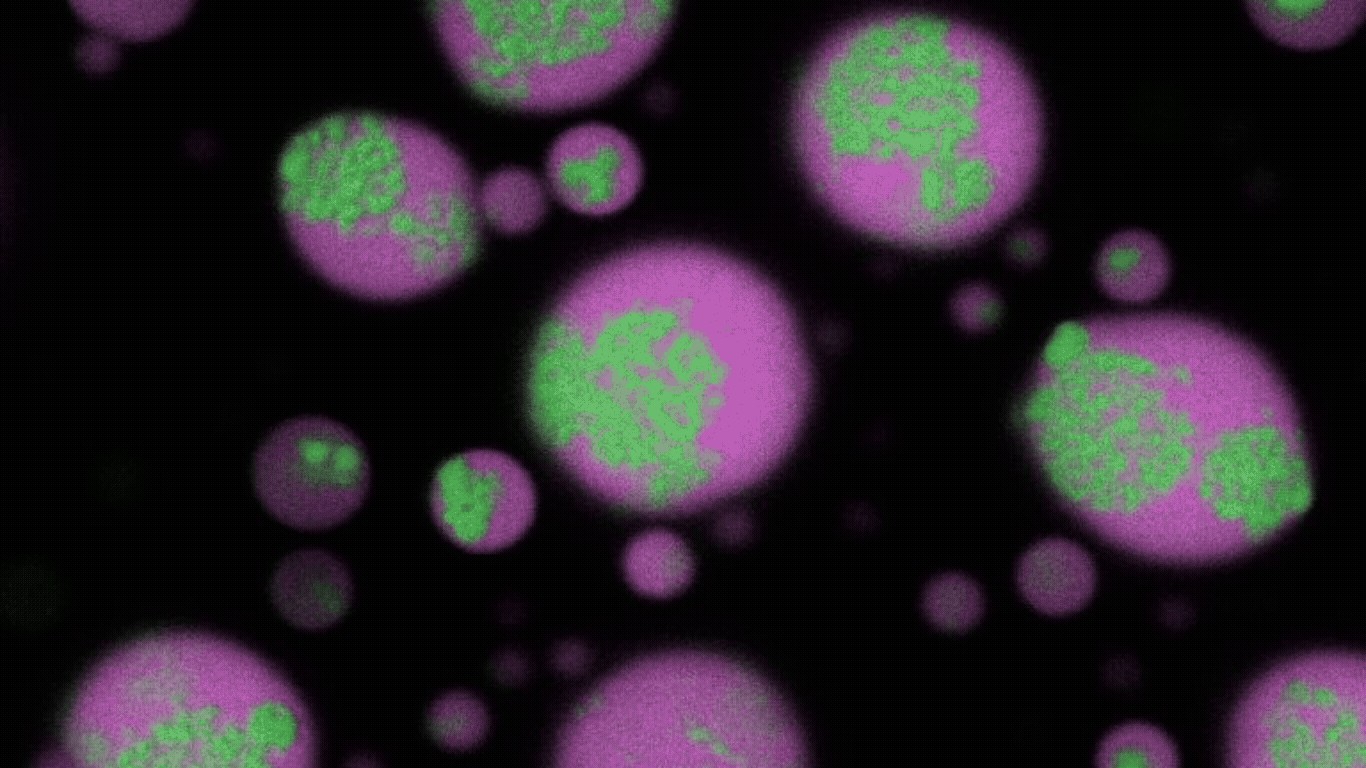

Featured image credit: Department of Physics, The State University of New York at Buffalo.
Researchers at the University at Buffalo, New York have discovered a contributor to the formation of RNA clumps in the brains of Huntington’s disease and ALS patients. The findings, published in Nature Chemistry, also showed that these clusters could be prevented and untangled using antisense oligonucleotides (ASOs).
Clumps of RNA in the brain are indicators of both Huntington’s disease and ALS. These can pull in surrounding proteins, disrupting healthy brain function.
How the RNA clusters form was previously uncertain, but now the UB researchers think the answer lies in biomolecular condensates: membrane-less droplets made from RNA, DNA or proteins. Using microscopy and a model condensate system, they found that long strands of repeat RNA can find their way inside these condensates, over time clumping together and solidifying into an RNA-rich core surrounded by a fluid shell.
“Repeat RNAs are inherently sticky, but interestingly, they don’t stick to each other just by themselves because they fold into stable 3D structures. They need the right environment to unfold and clump together, and the condensates provide that,” said the study’s first author and PhD student, Tharun Selvam Mahendran.
He added: “Crucially, we also found that the solid-like repeat RNA clusters persist even after the host condensate dissolves. This persistence is partly why the clusters are thought to be irreversible.”
Corresponding author Priya Banerjee, an associate professor in the Department of Physics at UB said: "What's exciting about this discovery is that we not only figured out how these clusters form but also found a way to break them apart."
First, the team looked at potential methods for preventing the formation of clusters in the first place, using the RNA-binding protein G3Bp1.
Banerjee said: “The RNA clusters come about from the RNA strands sticking together, but if you introduce another sticky element into the condensate, like G3BP1, then the interactions between the RNAs are frustrated and clusters stop forming.”
To reverse clusters which had already formed, the researchers employed ASOs with complementary sequences to the repeat RNA which make up the clumps. They found that the ASOs were able to bind to and disentangle the RNA clusters.
“This suggests our ASO can be tailored to only target specific repeat RNAs, which is a good sign for its viability as a potential therapeutic application,” Banerjee said.